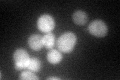
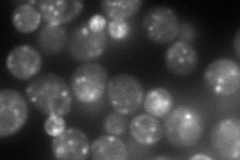
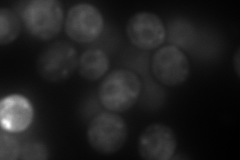
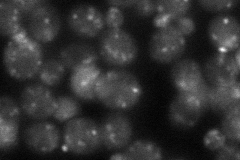

View description
GTPase of the Ypt/Rab family, very similar to Ypt32p; involved in the exocytic pathway; mediates intra-Golgi traffic or the budding of post-Golgi vesicles from the trans-Golgi
Localization:
Intensity:
Fold change:
Significance:
-
C’ GFP library in SD
cytosol61.51 -
N' NOP1pr-GFP in SD
punctate143.409 -
N' TEF2pr-mCherry in SD
ER,punctate311.713 -
N' NATIVEpr-GFP in SD
punctate57.0003 -
N' TEF2pr-VC and Cyto-VN in SD

ER,punctate53.913 -
C’ GFP library in SD+DTT

cytosol52.530.85No -
C’ GFP library in SD+H2O2

cytosol53.960.87No -
C’ GFP library in Starvation Media

cytosol74.781.21No -
C’ GFP library on the background of Pup2-DaMP

cytosol -
C’ GFP library on the background of CCT mutant

cytosol48.80510.793334No
